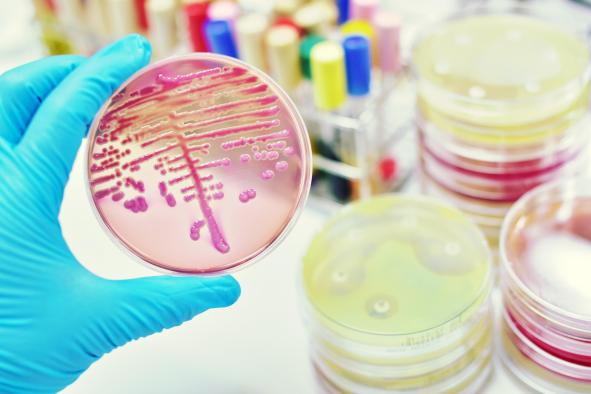
Master in molecular microbiology

Master 120 in Molecular Microbiology, à finalité approfondie
-
Horaire
horaire de jour
- Crédits ECTS 120

Présentation
L’étude des microbes est cruciale pour relever les défis futurs en matière de santé humaine et animale (multirésistance et résistance aux antibiotiques ; dysbiose du microbiote ; pathogènes microbiens émergents), de pollution (bioremédiation ; énergie verte) et de biotechnologie (microbiologie synthétique et micro-biotechnologie ; microbiologie alimentaire).
Unique en Belgique, le master en molecular microbiology (MMM) offre l’opportunité d’étudier le monde microbien dans le contexte de la recherche fondamentale et appliquée, vous permettant ainsi de faire face à tous ces défis importants du 21ème siècle.
Vos objectifs
- comprendre et aborder une grande diversité de processus moléculaires qui sous-tendent les interactions des microbes avec leur environnement ;
- gérer les aspects techniques et conceptuels d’un projet de recherche en microbiologie moléculaire (conception du projet, stratégies expérimentales, analyse critique des données, discussion et communication) ;
- faire preuve d’un grand intérêt pour la mobilité internationale et la collaboration avec des groupes de recherche internationaux.
Pourquoi s’inscrire au MMM ?
- le MMM est entièrement dispensé en anglais, ce qui facilite et encourage la mobilité internationale des étudiants ;
- vous apprendrez les approches de pointe de la microbiologie cellulaire et moléculaire, de la biochimie et de la bio-informatique appliquées aux microbes ;
- vous aurez accès à des groupes de recherche dynamiques en microbiologie moléculaire ;
- des conférenciers invités vous feront découvrir le monde de l’industrie et des hôpitaux ;
- le MMM fait partie d’un programme européen commun en bactériologie moléculaire.
Pourquoi étudier à l'UNamur ?
- l’UNamur valorise l’apprentissage actif et la disponibilité du personnel académique est toujours très appréciée par les étudiants ;
- l’UNamur est facilement accessible : 5 minutes à pied de la gare, 1 heure de l’aéroport de Bruxelles National ou de l’aéroport de Bruxelles Sud par les transports en commun ;
- l’UNamur est située au centre de la ville de Namur, agréable et paisible, avec son éventail d’activités culturelles et sportives et la proximité d’une belle campagne.
Le programme
Le master en molecular microbiology (MMM) est un programme de master orienté vers la recherche (120 crédits) entièrement dispensé en anglais. L’intégration du MMM dans un programme européen commun en association avec
- l’Université d’Aix Marseille,
- la Marburg Phillips-Universität,
- l’Université de Toulouse Paul Sabatier,
- la Tartu University,
- la Radboud University
- l’Université de Lausanne
favorise la mobilité internationale et donne accès à un large éventail d’expertise scientifique dans deux des plus prestigieux instituts européens de recherche en microbiologie.

1er semestre
Le premier semestre est consacré à des cours de microbiologie générale et spécialisée dispensés par des scientifiques du monde universitaire et de l’industrie qui abordent les éléments essentiels de la microbiologie moléculaire, avec un accent particulier sur la bactériologie.
Vous aurez l’occasion d’utiliser des méthodes d’apprentissage actif telles que l’apprentissage par problèmes, les classes inversées et les cours pratiques intégrés. Vous aurez également la possibilité d’assister à des conférences scientifiques locales et nationales.
2e – 4e semestre
Les trois derniers semestres sont consacrés à des projets de recherche dans plusieurs groupes de recherche au sein de l’UNamur et dans des laboratoires partenaires.
Au cours du deuxième semestre, l’accent est mis sur l’acquisition de compétences techniques en microbiologie moléculaire et sur les bases de la rédaction scientifique. Ces compétences seront développées au cours du troisième semestre dans le cadre de votre mémoire de Master, où vous améliorerez votre autonomie et votre communication scientifique.
Au cours du dernier semestre, vous aurez la possibilité d’effectuer un stage professionnel dans l’industrie ou dans un laboratoire de recherche académique à l’étranger.
Les autres masters en biologie
L’Université de Namur organise
- le master en biochimie et biologie moléculaire et cellulaire
- le master en biologie des organismes et écologie, à finalité approfondie
- le master in molecular microbiology
- le master 60 en sciences biologiques
-
Research activities
Code Nom Professeur(s) Th.+Ex. Crédits/Bloc 1 2 SMMMM109 Research Initiation (Biblio and/or Lab Work) De Bolle Xavier Matroule Jean-Yves Lima Mendez Gipsi Hallez Régis Renzi Francesco 22 SBIOM104 Intensive Integrated Practical Courses Renzi Francesco De Bolle Xavier 80h ex. 3 Soft skillsSMMMM113 Professional English (level B2+) Bouchat Hélène 10h th. 2 SMMMM201 Master Thesis Hallez Régis Renzi Francesco Lima Mendez Gipsi Matroule Jean-Yves De Bolle Xavier 30 -
Research focus
Code Nom Professeur(s) Th.+Ex. Crédits/Bloc 1 2 SMMMM202 Internship (Research Lab/Industry) Renzi Francesco Matroule Jean-Yves De Bolle Xavier Lima Mendez Gipsi Hallez Régis 30 -
Lectures
-
General Considerations in Molecular Microbiology
Code Nom Professeur(s) Th.+Ex. Crédits/Bloc 1 2 SMMMM110 Microbiology Basics Hallez Régis 30h th. 4 SMMMM116 Genomics and bioinformatics Lima Mendez Gipsi 22h th. + 22h ex. 5 SMMMM115 Applied and Synthetic Microbiology Lima Mendez Gipsi 22h th. 3 SVETM209 Molecular Virology Gillet Nicolas Muylkens Benoît 15h th. 2 SBIOM201 Parasitology Dujardin Jean-Claude 15h th. 2 SMMMM114 Eukaryotic Microorganisms Yague-Sanz Carlo 15h th. 2 -
Bacterial Topics
Code Nom Professeur(s) Th.+Ex. Crédits/Bloc 1 2 SBIOM136 Bacterial Cell Biology Matroule Jean-Yves 22h th. 2 SBIOM132 Bacterial Genetics and Evolution De Bolle Xavier 22h th. 2 SMMMM125 Chemistry of the bacterial cell Matroule Jean-Yves 15h th. 2 Soft skillsSMMMM121 Antibiotics, from Origin to Resistance Lima Mendez Gipsi 15h th. 2 SMMMM120 Pathogens and Epidemiology Renzi Francesco 22h th. 3 SMMMM119 Bacterial Stress Response and Signalling Hallez Régis 15h th. 2 Soft skillsSMMMM122 Microbial interactions and communities Lima Mendez Gipsi 15h th. 2
-
-
Research activities
Code Nom Professeur(s) Crédits Heures/Quadri 1 2 SMMMM109 Research Initiation (Biblio and/or Lab Work) De Bolle Xavier Matroule Jean-Yves Lima Mendez Gipsi Hallez Régis Renzi Francesco 22 SBIOM104 Intensive Integrated Practical Courses Renzi Francesco De Bolle Xavier 3 80h ex. Soft skillsSMMMM113 Professional English (level B2+) Bouchat Hélène 2 10h th. -
Lectures
-
General Considerations in Molecular Microbiology
Code Nom Professeur(s) Crédits Heures/Quadri 1 2 SMMMM110 Microbiology Basics Hallez Régis 4 30h th. SMMMM116 Genomics and bioinformatics Lima Mendez Gipsi 5 22h th. + 22h ex. SMMMM115 Applied and Synthetic Microbiology Lima Mendez Gipsi 3 22h th. SVETM209 Molecular Virology Gillet Nicolas Muylkens Benoît 2 15h th. SBIOM201 Parasitology Dujardin Jean-Claude 2 15h th. SMMMM114 Eukaryotic Microorganisms Yague-Sanz Carlo 2 15h th. -
Bacterial Topics
Code Nom Professeur(s) Crédits Heures/Quadri 1 2 SBIOM136 Bacterial Cell Biology Matroule Jean-Yves 2 22h th. SBIOM132 Bacterial Genetics and Evolution De Bolle Xavier 2 22h th. SMMMM125 Chemistry of the bacterial cell Matroule Jean-Yves 2 15h th. Soft skillsSMMMM121 Antibiotics, from Origin to Resistance Lima Mendez Gipsi 2 15h th. SMMMM120 Pathogens and Epidemiology Renzi Francesco 3 22h th. SMMMM119 Bacterial Stress Response and Signalling Hallez Régis 2 15h th. Soft skillsSMMMM122 Microbial interactions and communities Lima Mendez Gipsi 2 15h th.
-
-
Research activities
Code Nom Professeur(s) Crédits Heures/Quadri 1 2 SMMMM201 Master Thesis Hallez Régis Renzi Francesco Lima Mendez Gipsi Matroule Jean-Yves De Bolle Xavier 30 -
Research focus
Code Nom Professeur(s) Crédits Heures/Quadri 1 2 SMMMM202 Internship (Research Lab/Industry) Renzi Francesco Matroule Jean-Yves De Bolle Xavier Lima Mendez Gipsi Hallez Régis 30
Conditions d'admission
Si vous avez un diplôme belge
ACCÈS DIRECT
- bachelier en sciences biologiques ;
- master en sciences biologiques.
ACCÈS SUR DOSSIER
- bachelier en sciences biomédicales ;
- bachelier en médecine vétérinaire ;
- bachelier en sciences de l'ingénieur, orientation bioingénieur
- titulaire d'un diplôme délivré hors Union européenne.
Pour les admissions en master, il y a lieu de prendre contact avec le service des inscriptions.
Si vous avez un diplôme non belge
ACCESS BY APPLICATION
If you have a degree from an institution outside of Belgium, you will need to complete and return the admissions request form before 30 September (31 March for students from outside the European Union). Your level of English (minimum B2) must be confirmed by an official English certificate or through the online interview with the jury.
Jury
Description
Le master 120 en molecular microbiology, à finalité approfondie est un programme enseigné en anglais.
Pour plus d'information sur ce programme, veuillez consulter la version anglaise de cette page web.
Possibilités de carrières en microbiologie moléculaire
Le master en molecular microbiology ouvre les portes à des emplois dans de nombreux domaines de recherche liés à la microbiologie :
- votre expérience pratique de la recherche pendant 3 semestres vous fournira les qualifications nécessaires pour un futur emploi dans la recherche ;
- vous développerez un important réseau de contacts dans l'industrie et dans les hôpitaux, ce qui vous permettra d'entrer en contact avec ces communautés.